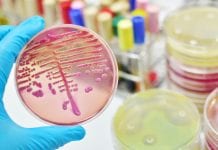
First global resolution on meningitis prevention and control First global resolution on meningitis prevention and control

Global Health Related News
Scale up of healthcare innovations for low- and middle-income countries
A strategic Collaborative Agreement to support the scaling up of healthcare innovations in low- and middle-income countries has been signed between the World Health...
UK offers genomics expertise to find new COVID-19 variants
The UK will be using its world-leading genomic expertise to help countries who do not have the resources to identify new variants of coronavirus.
Countries...
Health of women and children affected by armed conflict not addressed
New estimates have revealed that the health needs of 630 million women and children affected by armed conflict across the globe are not being...
COVAX to deliver two billion COVID-19 vaccine doses by end of 2021
COVAX has announced the aligning of an advanced purchase agreement for up to 40 million doses of the Pfizer-BioNTech vaccine, meaning it is now...
Reducing cardiovascular and cerebrovascular deaths with AstraZeneca
AstraZeneca’s recent THALES Phase III trial has demonstrated the efficacy of the drug Brilinta for reducing the risk of major cardiovascular events such as...
First global resolution on meningitis prevention and control
A global roadmap to defeat meningitis by 2030 has been established under the leadership of the World Health Organization.
At the 73rd Session of the...
Advancing global COVID-19 research with the WHO
Scientists across the globe have come together to intensify research into COVID-19.
The World Health Organization (WHO) is moving to expand its scientific collaboration and...
New global health insurance card for British citizens
The UK has launched a new Global Health Insurance card (GHIC) as part of the new UK-EU deal.
The UK has made a new agreement...
Global Ebola vaccine stockpile now established
A global stockpile of Ebola vaccines has now been established by four of the leading health and humanitarian organisations.
Led by the International Coordinating Group...
WHO lists Pfizer/BioNTech COVID-19 vaccine for emergency use
As more countries across the globe begin rolling out their mass COVID-19 vaccination programmes, the World Health Organization (WHO) has now listed the Pfizer/BioNTech...
XPhyto Therapeutics celebrates a PCR testing breakthrough
XPhyto Therapeutics has announced its ability to significantly speed up testing for COVID-19 using widely available PCR equipment.
As vaccines begin to roll out in...
Global leaders advocate urgent action on antimicrobial resistance
As the antimicrobial resistance crisis accelerates across the globe, world leaders are advocating for urgent action to combat the problem.
The leaders, including the heads...
Advancing the UN Sustainable Development Goals with Elsevier
Elsevier, the global information analytics company and academic publisher, specialising in science and health, recently published a landmark report to strengthen the understanding of...